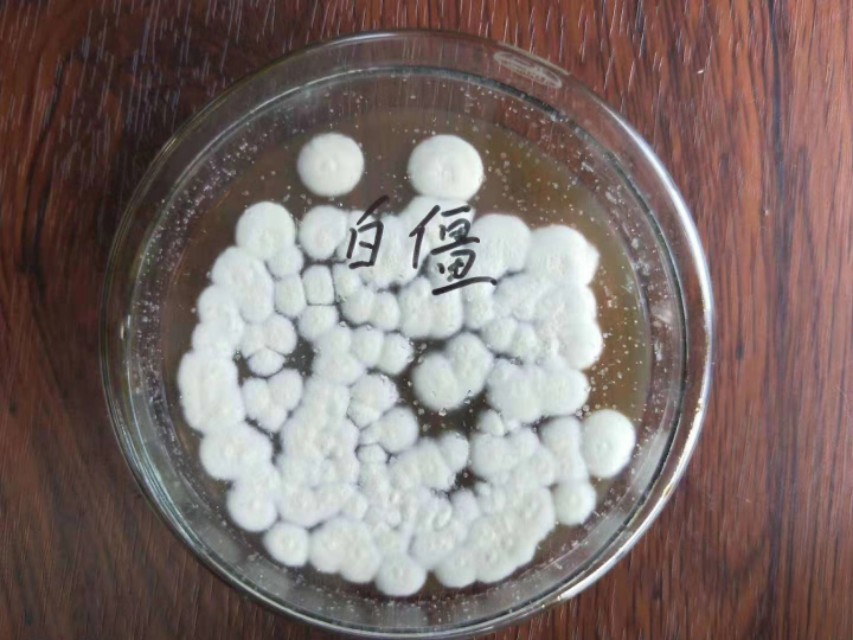
白僵菌怎么治地下害虫,白僵菌治韭蛆使用方法

韭蛆是指韭菜迟眼蕈蚊和葱蝇。两者都以幼虫在土壤中危害韭菜的地下假茎、根茎,使之腐烂,导致地上部枯黄死亡,严重时会形成大片枯死的韭丛。韭蛆是韭菜生产中最主要、最难治的虫害。
幼虫先取食韭菜叶鞘基部的嫩茎上端,春、秋两季主要为害韭菜嫩茎,致使韭菜的根基腐烂,地上部分生长细弱,叶片枯黄萎蔫下垂,最后有机韭菜叶枯黄而死;夏季高温时向下移动,蛀入鳞茎取食,严重时鳞茎腐烂,整墩枯死。
韭菜一旦被韭蛆为害,韭菜苗便枯萎不能萌发新芽,有的即使萌发了新芽,但长势细弱,要经过1到2年的修复期才能恢复正常生长,严重影响了韭菜的生产。
目前,在很多地区已经禁止了一些有机磷类农药,但是农户依然还是偷偷摸摸的使用,尽管如此,防效也是不甚理想。而白僵菌生物防治是国内应用最早的杀虫真菌,寄主范围极广,在地蛆体壁萌发,并能产生芽管侵入害虫体内,在害虫体内产生菌丝,影响血液循环、干扰新陈代谢,导致害虫死亡。且害虫不宜产生抗性。连年使用,效果更好。安全无污染,可明显防治多种作物的地蛆。

白僵菌:白僵菌是我国研究时间最长和应用面积最大的真菌杀虫剂。球孢白僵菌是害虫微生物防治中一种经典的丝孢类虫生真菌,可侵染15目、149科的700多种昆虫和若干种蛛螨类。截至2010年,在全世界范围登记的球孢白僵菌微生物农药就有41种。昆虫病原真菌是唯一通过昆虫表皮侵染的杀虫微生物。
白僵菌侵染昆虫主要有3个过程:孢子接触到虫体后在适宜的温度和湿度条件下萌发;透过昆虫表皮入侵到昆虫体内;在昆虫体内利用昆虫营养生长繁殖并分泌毒素直至昆虫得病死亡。
虫尸上的孢子又可借助风力扩散,或被害虫主动接触虫尸,继续侵染其他害虫个体。使疫病蔓延造成害虫大量死亡。
白僵菌杀虫剂主要杀什么虫?
白僵菌的寄主很多,可防治对象有玉米螟、松毛虫、蛴螬、多种金龟子、水稻叶蝉、飞虱、桑天牛、茶毛虫、大豆食心虫和蚜虫、蝗虫、马铃薯甲虫、松褐天牛、白蚁、茶小绿叶蝉、桃小食心虫等等,特别是对玉米螟、松毛虫和蛴螬,已作为常规手段连年使用。

1、白僵菌防治玉米螟
将100亿孢子/克可湿性粉剂350克与5千克细沙子或炉渣(20-30筛目)混合均匀制成颗粒剂,在玉米螟卵孵化盛期逐棵投放玉米心叶内,每株1一2克(每亩约4万亿孢子)。
2、松毛虫
亩用100亿孢子/克可湿性粉剂200克,可喷粉可喷雾。
3、蛴螬
在花生播种和中耕两个时期,亩用100亿孢子/克可湿性粉剂250-300克与30千克细土混拌成菌土,撒施或者进行灌根!
4、蔬菜蚜虫
亩用100亿孢子/毫升油悬浮剂100-120毫升进行超低容量喷雾。常量喷雾时,一般是将菌粉配制成每毫升含活孢1亿以上的菌液,或将病死的虫尸100头研磨成粉,对水80-100升,再加菌液0.0l%的洗衣粉进行喷雾。
5、茶小绿叶蝉
亩用100亿孢子/毫升油悬浮剂100-120毫升进行超低容量喷雾。
6、防治桃小食心虫
亩用700亿袍子对水后喷洒树冠下地面,为提高防效可于喷后盖草,使出土幼虫大量僵死。

在中国,白僵菌防治最成功的是森林、苗圃、草坪、农田等的蛴螬、玉米螟、松毛虫、茶小绿叶蝉等。仅蛴螬、玉米螟、茶小绿叶蝉三种就已构成了巨大的潜在市场。
目前人民对健康要求越来越高,有机和绿色农产品才是最好的选择。从天然产物资源中发掘新颖杀虫剂是对环境友好,人、畜安全的可持续发展之路。目前从天然产物开发杀虫剂在当前要求建设资源节约型、环境友好型社会,要求大力发展绿色农业、环保农业的全球大环境下,微生物农药无疑是今后农药的发展方向之一。